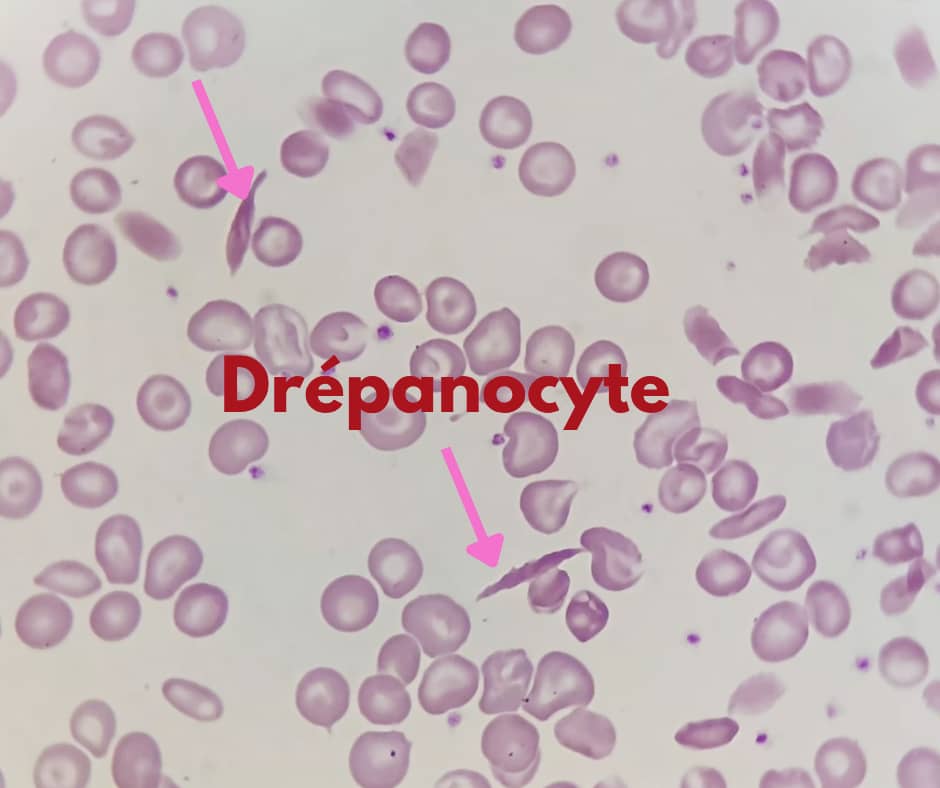
al shamel lab tenes 17
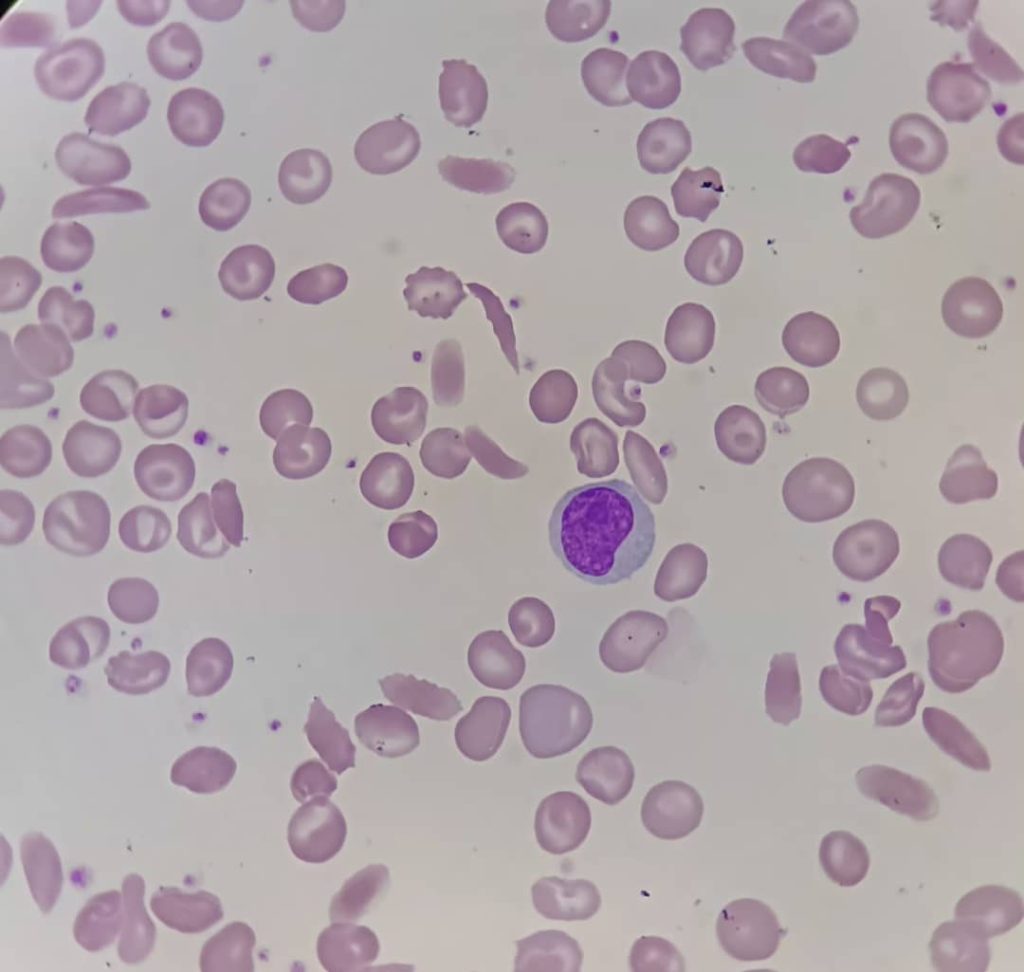
al shamel lab tenes 5
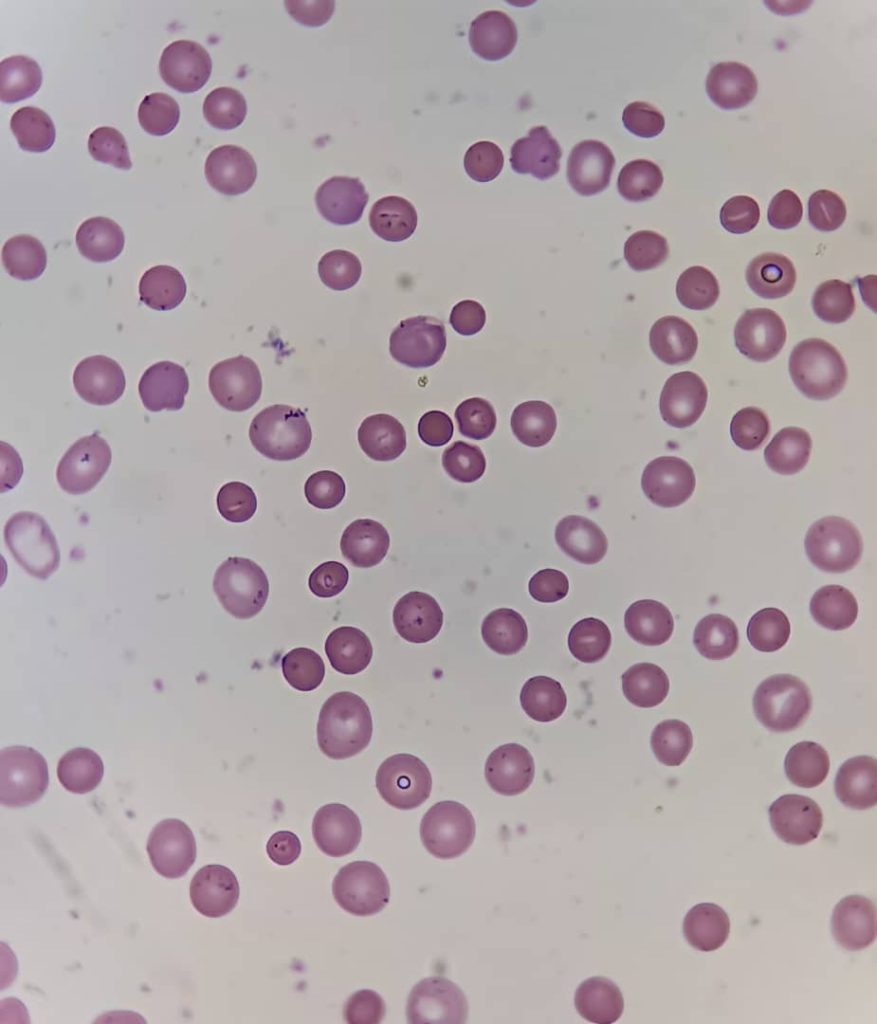
al shamel lab tenes 7
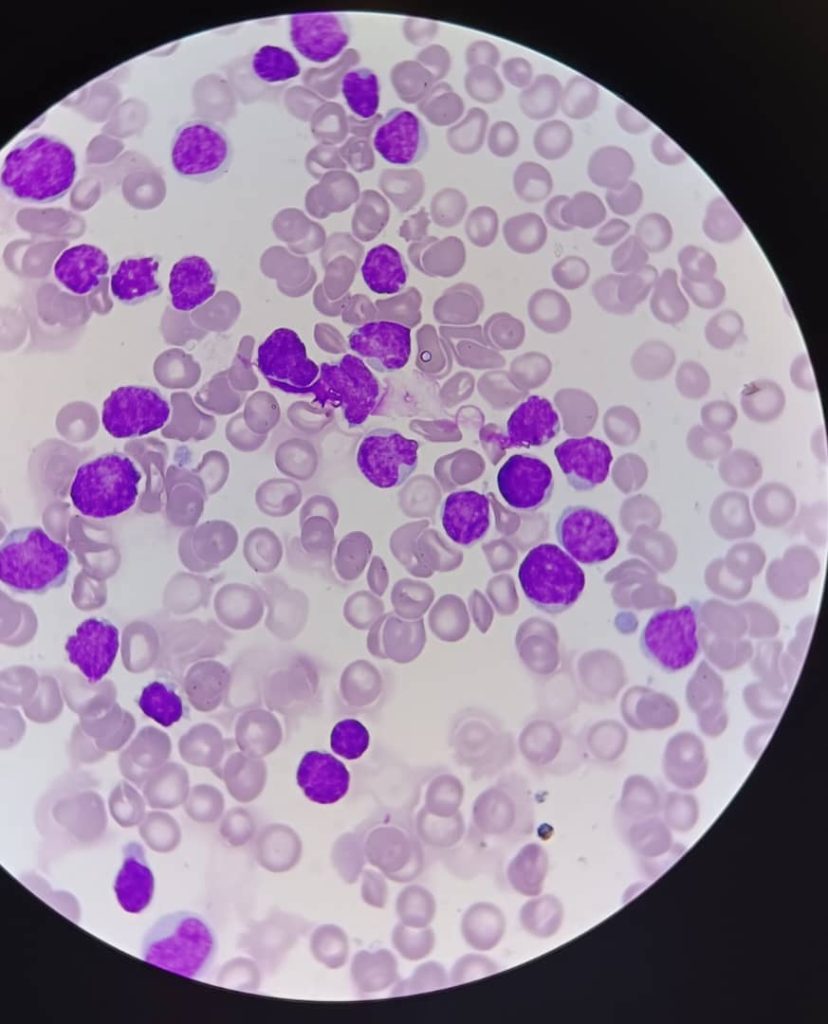
al shamel lab tenes 12
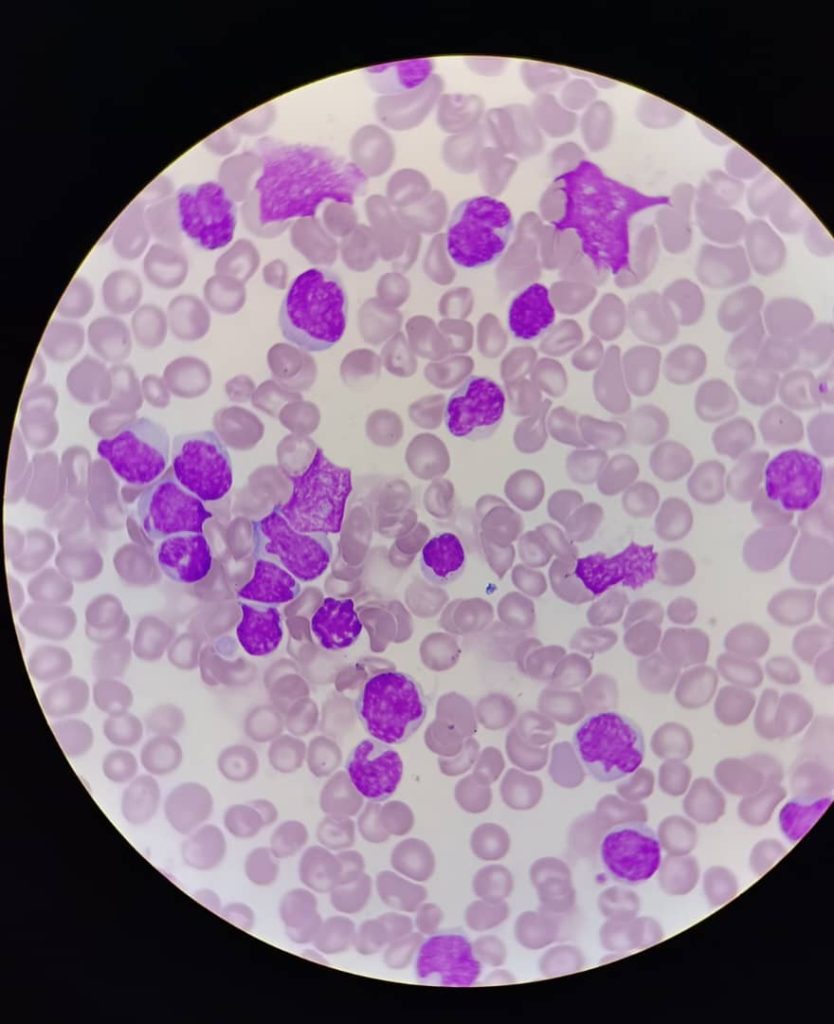
al shamel lab tenes 14
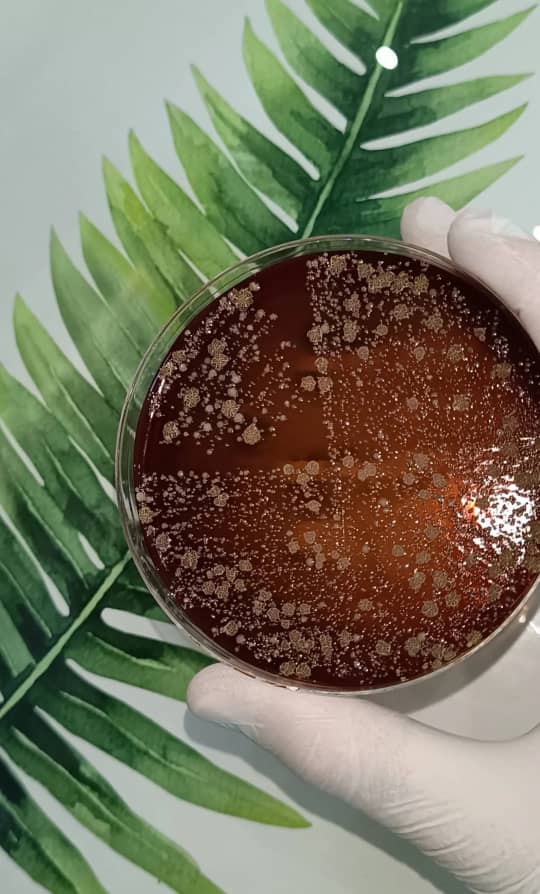
al shamel lab tenes 22
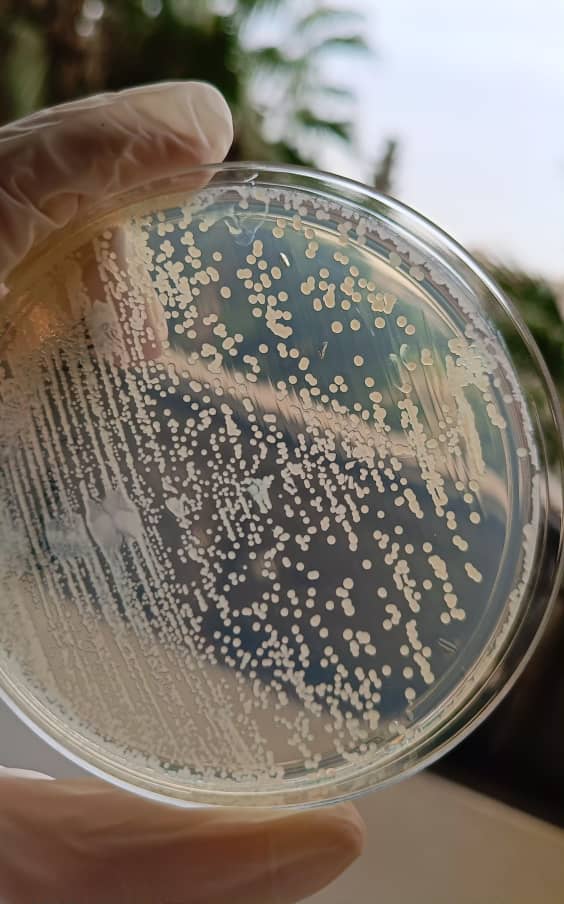
al shamel lab tenes 35
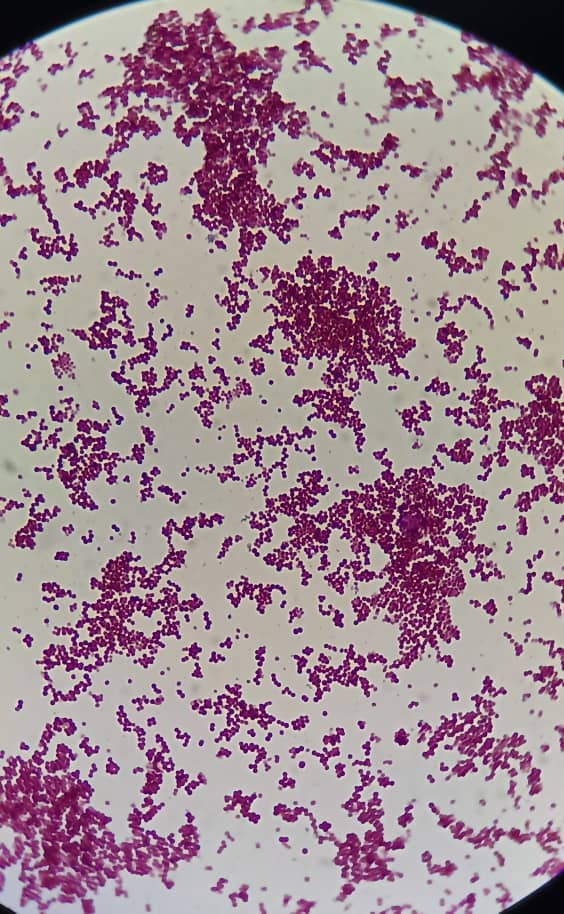
al shamel lab tenes 25
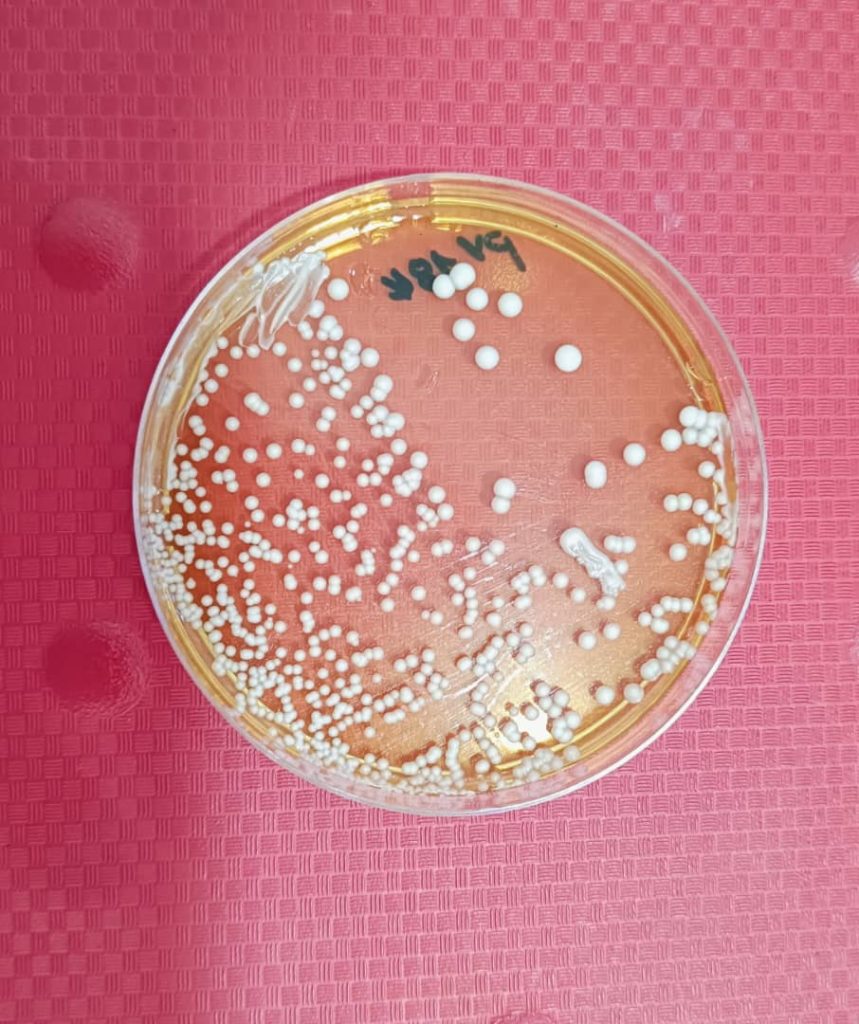
al shamel lab tenes 26

Dr MOSTEFA CHEBRA .G
Epse Boudjelthia
الدكتورة مصطفى شبرة .غ
زوجة بوجلطية
Médecin spécialiste en hématologie
(Hématologue)
دكتورة متخصصة في أمراض الدم
AL SHAMEL LAB
Laboratoire d’analyses médicales et Hématologie
مخبر الشامل
للتحاليل الطبية و أمراض الدم
| dimanche | 07h30 – 16h00 |
|---|---|
| lundi | 07h30 – 16h00 |
| mardi | 07h30 – 16h00 |
| mercredi | 07h30 – 16h00 |
| jeudi | 07h30 – 16h00 |
| vendredi | Fermé |
| samedi | 07h30 – 16h00 |
| Les anémies |
| Anémies congénitales, anémies acquises: y compris carentielles, auto-immunes, inflammatoires ou autres |
| Les pathologies de la rate et les ganglions lymphatiques |
| La splénomégalie, les hyperleucocytoses, leucémies, lymphomes, autres pathologies… |
| Les troubles de la coagulation |
| Diagnostic des thrombopathies, déficit en facteurs de coagulation, maladie de Willebrand… |
| Onco-hématologie |
| Diagnostic des leucémie aigue, syndromes lymphoprolifératifs et myéloprolifératifs chronique, (LAM, LAL, LLC, LMC, Lymphomes…) |
| Ponction et biopsie ostéo-médullaire |
| BOM dans les meilleurs conditions sous Anésthésie locale. Myélogramme avec études cytologiques détaillées. |
| Autres |
| Les thrombopénies, thrombocytoses, thrombophilie, les troubles hématologiques chezla femme enceinte… |
| Biochimie |
| Hématologie |
| Hormonologie |
| Sérologie |
| Allergologie |
| Immunologie |
| Microbiologie |
| Spermiologie |
| Marqueurs tumoraux et cardiaques |
| Biologie moléculaire |
| PCR |
| Test Antigénique COVID19 |
| Sérologie COVID19 |
| Préleveurs Qualifiés |
| Préleveurs Qualifiés en Pédiatrie |
| Prélèvements à domicile |
| Troponine |
| INR |
| Béta HCG |
| D-dimères |
| Lipase – Amylase |
| Autres paramètres sur demande du Médecin |
Adresse: Hay ouled l3am koubili en face la branche communale centrale, Tenès- Chlef
العنوان: حي اولاد العم قوبيلي مقابل الفرع البلدي المركزي، تنس-الشلف